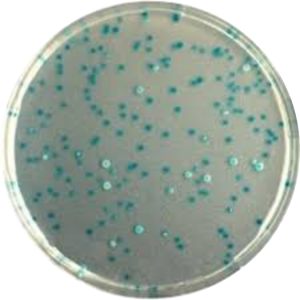

SYMPTOMS OF CHOLERA
Vibrio Cholerae can cause acute watery diarrhea, in most cases it can become fatal within hours if not treated. The symptoms of Vibrio Cholerae appear between the timeline of 12 hours and 120 hours after being infected by it.
Acute watery diarrhea is a main symptom of Vibrio Cholera, but there is also other symptoms that can indicate the presence of this infection/disease:
Vomiting
Vomiting is the for forcible emptying (“throwing up”) of the stomach contents through your mouth. This usually happens when an unease is caused in your stomach, causing the muscles to contract and squeeze together. Vibrio Cholera produces a toxin that is called “Cholera toxin” CTX within the small intestine that will cause vomiting. This toxin causes the body to secrete enormous amount of water, leading to diarrhea and rapid loss fluid and salts
Dehydration
Dehydration can develop within a few hours after vomiting and other symptoms start and can range from mild dehydration to severe dehydration case. 10% or more of the patient’s body weight could be lost in the process. Because of the vomiting it can lead to severe dehydration, which can be serious and life threatening as well. The rapid loss of fluids and electrolytes after diarrhea, is also a main cause of dehydration.
Fatigue
Fatigue is one of the symptoms that will let you feel like you have an overwhelming urge to sleep, but you will not feel refreshed after you rest or sleep. The loss of electrolytes and fluids after diarrhea and vomiting leads to weakness and fatigue in a patient’s muscles. Muscles within the human body use electrolytes (Sodium, Calcium, etc.) to contract and relax, but if there is a loss of these electrolytes, fatigue is caused.
Muscle Cramps
Because of the vomiting, you will experience involuntary and forcibly contractions from you muscles, indicating an underlying neurological condition. The loss of specific electrolytes (such as potassium, calcium and sodium) through vomiting & diarrhea, causes the skeleton muscles not to function correctly, leading to muscle cramps in the skeleton muscles of the legs and arms.
Dizziness
A woozy and disoriented feeling, that’s how dizziness feels like. This symptom mostly occurs because of the dis-ease in your central nervous system caused by vibrio cholerae. Vomiting causes dizziness, by loss of fluids and electrolytes which leads to low blood pressure that can cause dizziness and goes as severe as fainting.
Tachycardia
An abnormal heart rhythm, with a heart rate reaching even more than 100 beats per minute at rest! After there is a drop in the blood pressure of a patient, that was caused by a loss of electrolytes, will result in the heart of a patient trying to compensate for the low blood pressure by pumping faster than usually.
With all these symptoms that I’ve indicated, it’s important that you remember that most people who are infected with the bacteria Vibrio cholerae do not usually show symptoms but can still spread it.
DIAGNOSIS OF CHOLERA
Culture Media
When cholera is common in certain areas, symptoms cannot be mistaken. However, the diagnosis can only be confirmed after the bacteria were identified in a stool sample of the possible infected person.
In most cases, a stool/rectal swab is extracted. Culture media such as Agar plates in the images below are used to grow and cultivate the bacteria in order to determine the identity of microorganisms. Various mediums can be used that are selective to certain bacteria and therefore aid in the identification and diagnosis procedures. Selective mediums for Vibrio cholerae include Thiosulfate Citrate Bile Sucrose Agar or Tauroxholate Tellurite Gelatin Agar. Another culture media used for identification and differentiation is the CHROMagar or chromogenic agar. Vibrio cholerae appears turquoise blue.
The String Test
Vibrio cholerae is one of two Vibrio species that does not require salt (non-Halophilic). This unique characteristic makes it easier to identify and differentiate between similar organisms. The string test is used as a time-efficient diagnostic tool: the specimen is mixed with 0.5% sodium deoxycholate. This causes the DNA within the cell to become exposed. When the mixture is touched with a “stick” (inoculating loop), the solution forms a string – therefore, it has a positive outcome.
Vibrio cholerae will have an extensive string that makes it distinctive and, therefore a positive test. It can be concluded that a specimen is not Vibrio cholerae and therefore has a negative test if no string is formed.
Rapid Diagnostic Tests
In well-developed settings, most healthcare providers rely on the results from the stool culture and rapid tests like the Crystal VC Rapid Diagnostic Test , which detects Vibrio cholera bacteria in stool samples. In areas where cholera is endemic, rapid immunochromatographic dipstick testing is often available. This involves placing a dipstick strip into a stool sample and then reading the lines it displays. Cholera is confirmed if two red lines appear on the stick. This usually takes between 2-15 minutes for the test to make a diagnosis. There are two surface antigens for Vibrio Cholera, which is responsible for cholera epidemics. They are known as serogroup O1 and serogroup O139.
In some cases, cholera is suspected if someone has acute water diarrhea more than 3 times with or without vomiting within 24 hours.
Furthermore, other ways of doing diagnosis for cholera includes the moleculer test. This is feasible. For practical use, this has been limited to epidemiologic research and surveillance. Dark field microscopy is an alternative option for testing. This involves rice-water stools which is viewed at 400x magnification. Motile vibrios are monitored with the addition of specific antibodies. This method is highly specific for Vibrio Cholerae.

References
https://www.mayoclinic.org/diseases-conditions/cholera/symptoms-causes/syc-20355287
https://my.clevelandclinic.org/health/diseases/16636-cholera
https://www.uptodate.com/contents/cholera-epidemiology-clinical-features-and-diagnosis#H938291637
https://www.mayoclinic.org/diseases-conditions/cholera/diagnosis-treatment/drc-20355293 https://www.news-medical.net/health/cholera-Diagnosis.aspx https://pmc.ncbi.nlm.nih.gov/articles/PMC9491185/